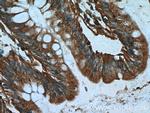
DTX1 Antibody in Immunohistochemistry (Paraffin) (IHC (P))

Search
Proteintech
DTX1 Polyclonal Antibody
{{$productOrderCtrl.translations['antibody.pdp.commerceCard.promotion.promotions']}}
{{$productOrderCtrl.translations['antibody.pdp.commerceCard.promotion.viewpromo']}}
{{$productOrderCtrl.translations['antibody.pdp.commerceCard.promotion.promocode']}}: {{promo.promoCode}} {{promo.promoTitle}} {{promo.promoDescription}}. {{$productOrderCtrl.translations['antibody.pdp.commerceCard.promotion.learnmore']}}
产品信息
18350-1-AP
种属反应
宿主/亚型
分类
类型
抗原
偶联物
形式
浓度
规格
纯化类型
保存液
内含物
保存条件
运输条件
产品详细信息
This antibody recognizes DTX1 protein (72 kDa) and it's isoforms (about 60 kDa).
Immunogen sequence: MSRPGHGGL MPVNGLGFPP QNVARVVVWE WLNEHSRWRP YTATVCHHIE NVLKEDARGS VVLGQVDAQL VPYIIDLQSM HQFRQDTGTM RPVRRNFYDP SSAPGKGIVW EWENDGGAWT AYDMDICITI QNAYEKQHPW LDLSSLGFCY LIYFNSMSQM NRQTRRRRRL RRRLDLAYPL TVGSIPKSQS WPVGASSGQP CSCQQCLLVN STRAASNAIL ASQRRKAPPA PPLPPPPPPG GPPGALAVRP SATFTGAALW AAPAAGPAEP APPPGAPPRS PGAPGGARTP GQNNLNRPGP QRTTSVSARA SIPPGVPALP VKNLNGTGPV HPALAGMTGI LLCAAGLPVC LTRAPKPILH PPPVSKSDVK PVPGV (1-374 aa encoded by BC048216)
靶标信息
Studies in Drosophila have identified this gene as encoding a positive regulator of the Notch-signaling pathway. The human gene encodes a protein of unknown function; however, it may play a role in basic helix-loop-helix transcription factor activity.
仅用于科研。不用于诊断过程。未经明确授权不得转售。
生物信息学
蛋白别名: deltex 1, E3 ubiquitin ligase; deltex homolog 1; Deltex1; E3 ubiquitin-protein ligase DTX1; fractionated x-irradiation induced transcript 1; FXI-T1; mDTX1; Protein deltex-1; RING-type E3 ubiquitin transferase DTX1
基因别名: DTX1; Fxit1; hDx-1; mKIAA4160; RNF140
UniProt ID: (Human) Q86Y01, (Mouse) Q61010
Entrez Gene ID: (Human) 1840, (Rat) 687424, (Mouse) 14357